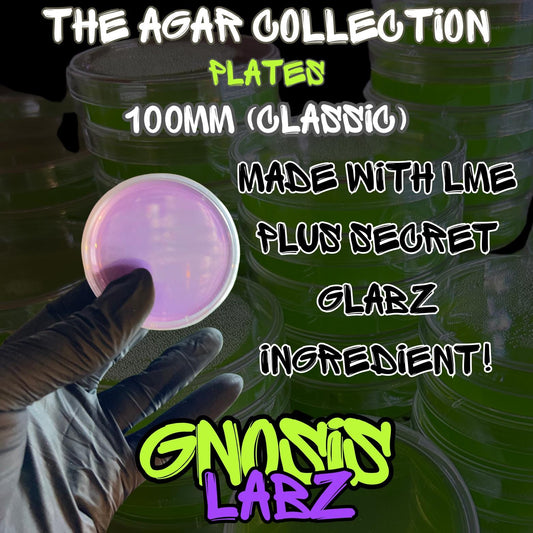
6 Pack of 100mm Agar Plates - Sterilized Agar Media Petri Dishes - Great for Larger Cultures (Different Colors Available) - Gnosis Labz Gnosis Labz Green
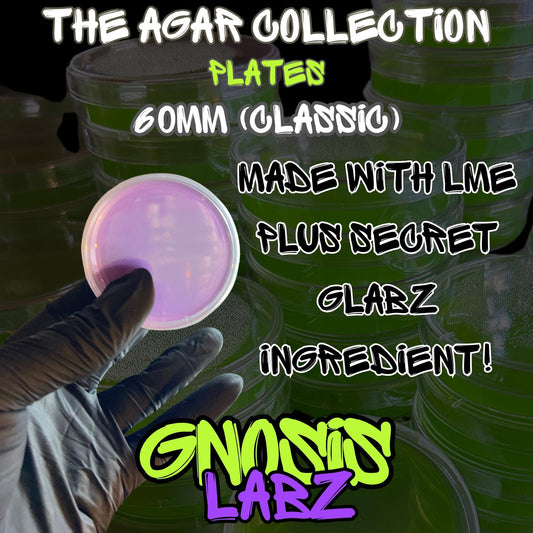
6 Pack of 60mm Agar Plates - Sterilized Agar Media Petri Dishes - Great for Small Cultures (Different Colors Available) - Gnosis Labz Gnosis Labz Green

-

6 Pack of 2oz Agar Cups - Sterilized Agar Media - Great for Small Cultures (Buy more save more!)
Vendor:Gnosis LabzRegular price $14.99 USDRegular price$24.99 USDSale price $14.99 USDSale -
Sterilized Liquid Culture Solution One Pint Jar -Modified lid with Injection Port and Filter Patch! Ready to Inoculate right away!
Vendor:Gnosis LabzRegular price $19.99 USDRegular price$24.99 USDSale price $19.99 USDSale -
One Dozen 100mm Agar Plates - Sterilized Agar Media Petri Dishes - Great for Larger Cultures (Different Colors Available)
Vendor:Gnosis LabzRegular price $22.99 USDRegular price$28.99 USDSale price $22.99 USDSale -
6 Pack of 100mm Agar Plates - Sterilized Agar Media Petri Dishes - Great for Larger Cultures (Different Colors Available)
Vendor:Gnosis LabzRegular price $15.99 USDRegular price$19.99 USDSale price $15.99 USDSale -
One Dozen 60mm Agar Plates - Sterilized Agar Media Petri Dishes - Great for Small Cultures (Different Colors Available)
Vendor:Gnosis LabzRegular price $19.99 USDRegular price$24.99 USDSale price $19.99 USDSale -

One Dozen 2oz Agar Cups - Sterilized Agar Media - Great for Small Cultures (Bundle Deals Available)
Vendor:Gnosis LabzRegular price $17.99 USDRegular price$24.99 USDSale price $17.99 USDSale -
6 Pack of 60mm Agar Plates - Sterilized Agar Media Petri Dishes - Great for Small Cultures (Different Colors Available)
Vendor:Gnosis LabzRegular price $12.99 USDRegular price$17.99 USDSale price $12.99 USDSale